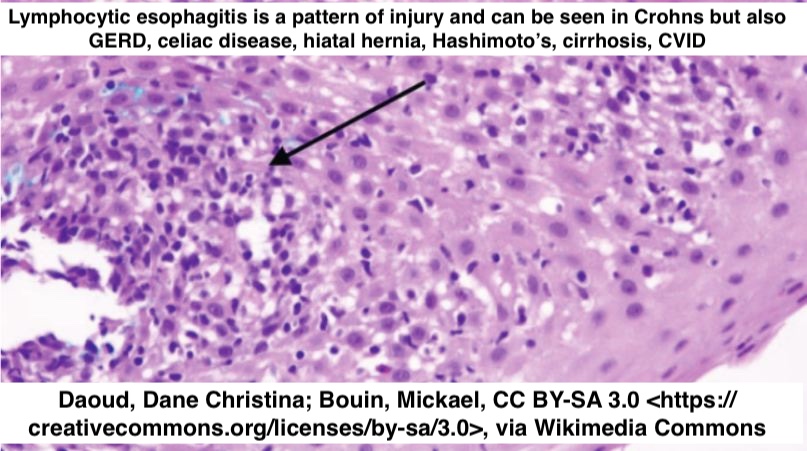

Mengxue Zhang,MD PhD (张梦雪)
@mengxuepath
PGY-3 @UChicagoPath🔬| CMP alumni, PhD @UWiscPathology | @CAPA_comm Online Education | 2026-2027 GI/Liver pathology fellow @UchicagoPath| Cat Mom 🐈🐈🐈🐈🐈
ID: 1227853241192472576
13-02-2020 07:13:41
482 Tweet
1,1K Followers
1,1K Following




📢 Join us this Sunday, 6/15 at 7PM ET for the next #CAPA CP session! Dr. Caitlin Otto (Caitlin Otto, PhD, D(ABMM)) from NYU GSOM Pathology will present “Infectious Disease in Anatomic Pathology”. A must-attend for pathology trainees & practicing pathologists! #PathTwitter




Congrats to Lindsay Yassan, MD who begins as AP associate program director of our residency Thanks to Anthony Chang, MD (張賀文) for serving in this role for 17 years!

New PBPS Case of the Quarter is live! PBPS members—check out the latest case and join the discussion. Log in to view and comment: pbpath.org/case-4-quarter… Michelle Reid MD Olca Basturk Diana Agostini-Vulaj Monika Vyas Pooja Navale MD Vidya Arole Feidi Chen Claudio Luchini


Join us this Sun, Aug 17, 7PM ET for CAPA OLE #Liverpath session with Dr. Xiaotang (Alison) Du Alison Du, MD: “Calm But Not Quiet: Near-Normal Injury in Medical Liver Disease.” Unravel subtle histology, tricky patterns & sign-out tips. Must-attend for GI/Liver lovers! #PathTwitter



The PBPS Journal Watch (June – August 2025) is out! Please log in to download, read, and track newly released articles in pancreatobiliary pathology: pbpath.org/current-journa… Michelle Reid MD Olca Basturk Diana Agostini-Vulaj Monika Vyas Raul S. Gonzalez, MD Huamin Wang, MD, PhD Claudio Luchini

New PBPS Case of the Quarter is live! PBPS members—check out the latest case and join the discussion. Log in to view and comment: (pbpath.org/case-5-quarter…)Michelle Reid MD Olca Basturk Diana Agostini-Vulaj Monika Vyas Raul S. Gonzalez, MD Huamin Wang, MD, PhD Claudio Luchini Pooja Navale MD Vidya Arole




I had a great time at day 1 of #CAP25 Chinese American Pathologists Association CAPathologists CAP Advocacy Moffitt Cancer Center